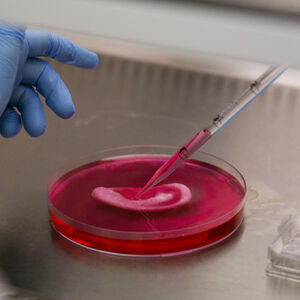

ne igrajte se
SRBI MASOVNO BACAJU TALOG OD KAFE U SUDOPERU, VEĆINA ŽENA PRAVI 1 KOBNU GREŠKU: Možete sebi da napravite PAKAO!
Osim što nije dobro u nju odlagati tanjire pune hrane, nije dobro ni u odvod puštati neke vrste namirnica i hemikalija jer može doći do oštećenja cevi
Sudoperu možete vrlo lako zapušiti i uzrokovati dalje probleme nekim svakodnevnim radnjama o kojima možda nikada niste razmišljali.
Osim što nije dobro u nju odlagati tanjire pune hrane, nije dobro ni u odvod puštati neke vrste namirnica i hemikalija jer može doći do oštećenja cevi.
Kako prenosi Hillcrestplumbing, prva stvar koju nikako ne biste trebali bacati u odvod je mast - vrlo je štetna za cevi, ali i za okolinu.
Može se stvrdnuti i stvoriti začepljenje koje se jako teško uklanja. Pričekajte da se zgusne i stvrdne na sobnoj temperaturi, a onda je bacite u kantu za smeće.
Jedna stvar koju većina baca u odvod je talog od kave, ali on se ponaša slično kao mast - deluje poput mulja i začepljuje vam odvod. Bacite ga u smeće ili iskoristite za kompost.
Ostatke hrane, a posebno kosti nikada ne bacajte u odvod. Kost može probušiti cev, a nakupljeni ostatci hrane će ga zapušiti. Za kraj, ako imate stare lekove, odnesite ih na specijalna odlagališta, na bacajte ih u odvod.
(Espreso / Novi.ba)
Uz Espreso aplikaciju nijedna druga vam neće trebati. Instalirajte i proverite zašto!